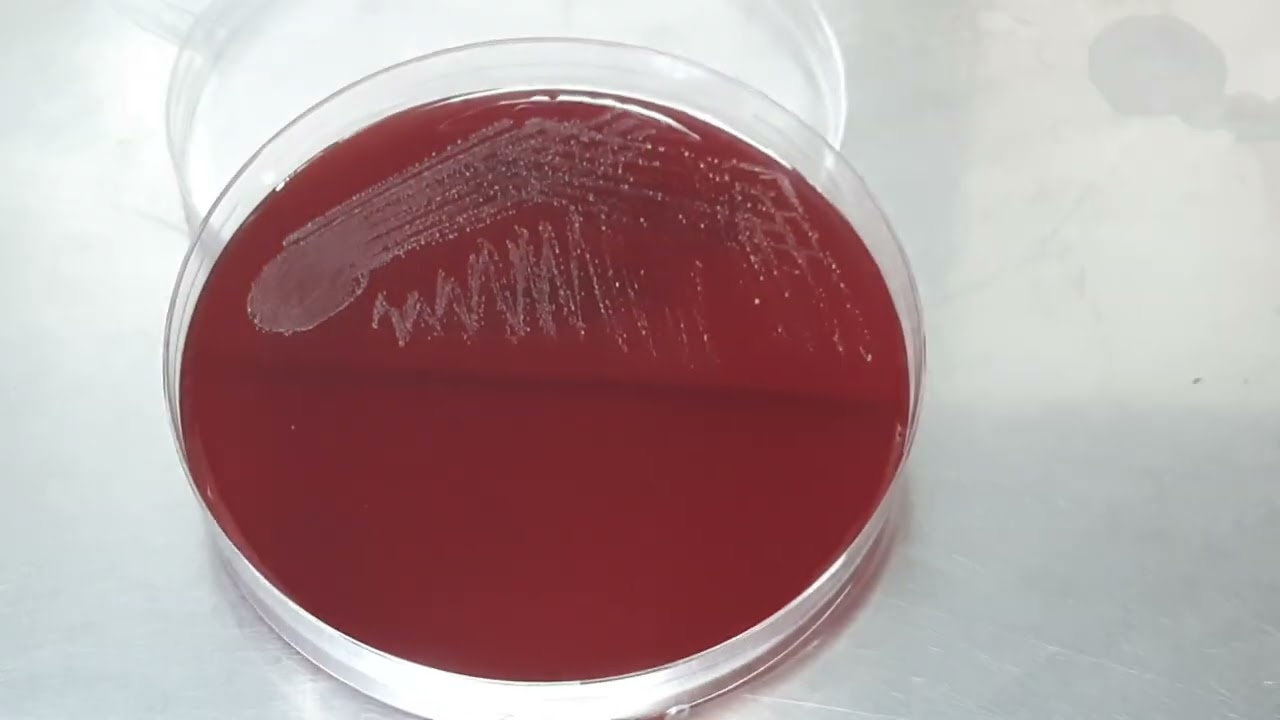

Loading song details...
CAMP Test Christie Atkins Munch Peterson Microbiology Laboratory Practicals Crashcourse
No description available.
MP3 Download
Video Download
Related Songs

1:01
CAMP Test Christie Atkins Munch Peterson Microbiology Laboratory Practicals Crashcourse

2:32
Why What Is CAMP Test Clear Explain

2:27
CAMP Test

10:28
CAMP Test Factor Reaction Microbiology Streptococcus Agalactiae

7:22
Camp Test In Microbiology

5:45
CAMP Test Simplified

1:08
CAMP Test For Streptococcus Agalactiae GBS

0:58
What Is CAMP Test

5:42
Camp Test Complete Details Modified

5:10
Christie Has Type 1 Diabetes And Shares How Lab Tests Help Her Manage Diagnosis

7:29
What Is CAMP Test A Biochemical For Identification Of Group B Hemolytic Streptococcus Species
0:15
Colony Characteristics Of Streptococcus Agalactiae On Blood Agar Urine Culture

3:02
Woman Experiences PTSD Episode While Speaking With Dr Phil

5:17
Reverse CAMP Test Clostridium Perfringens Microbiology

34:49
Satellitism CAMP Test Fortner S Plate SWAHILI VERSION SBK

1:56
Why Dr Phil Abruptly Ends Interview And Asks Guest To Leave Stage

41:51
Cathy And Christi Get Down Dirty S2 E26 Full Episode Dance Moms

3:53
CAMP Test In Hindi For Streptococcus Agalactiae Procedure Microbiology

0:12
Little Hidden Pearl Dancemoms Aldc Chloelukasiak Fyp Shorts

14:00